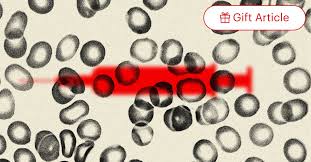

Skip to comments.
Honoring President Trump - Trump Family Train: July 1, 2024 – August 31, 2024
6/30/24
| CottonBall
Posted on 06/30/2024 6:40:07 PM PDT by CottonBall
ALL ABOARD THE TRUMP FAMILY TRAIN, EST. 2017 BY DOLLYCALI!
Survived everything thrown at it over the years, just like President Trump....including trolls, moles and saboteurs.

Welcome to the TRUMP FAMILY TRAIN THREAD, where all things Trump are welcome!
Feel free to share news, your comments and opinions, memes, recipes, travel photos... the list is endless.
Posting on behalf of the TFT founder and thread mama, Dolly Cali.







TOPICS: Breaking News
KEYWORDS: president; tft; train; trump; trumptrain
Navigation: use the links below to view more comments.
first previous 1-20 ... 681-700, 701-720, 721-740 ... 5,641 next last
To: Spunky
You have got to be kidding. Gerber is going woke as well....and right after I find out they’re just hanging in there, acting all normal lol.
Can you just imagine what the uproar would have been if the pancake jockies had decided that a black lady had been the face of Aunt Jemima pancake mix long enough, and they were pulling her and putting in a white lady? Good grief, the shrieking would have deafened the nation.
I’m like you - never bought or didn’t buy anything because of whatever face it was toting. Having said that, if they started slapping homosexual couples and drag queens or obvious weirdos on packages, I’d definitely go without it.
How’s the heat, Spunks? Still indoors, staying nice and cool and safe?
701
posted on
07/08/2024 12:25:51 PM PDT
by
JudyinCanada
(The left is loathsome, beyond anything I could have believed.)
To: Spunky
I tried to listen tothe WH brieding, and I must admit, I have never witnessed more old faced liars than KJP and Kirby. My GAWD, How can they live with themselves! I wish there were a way to get rid of all of them!
702
posted on
07/08/2024 12:28:13 PM PDT
by
MagUSNRET
((" I have loved the stars too fondly to be fearful of he night"))
To: JudyinCanada
Im just wAITING FOR THEM TO STOP SHOWING mY pILLOW ADS AND EVERYONE IN THE WORLD HAVING PSORIATIC ARTHRITIS!
703
posted on
07/08/2024 12:30:11 PM PDT
by
MagUSNRET
((" I have loved the stars too fondly to be fearful of he night"))
To: Spunky
I agree, Spunky. I’m so tired of hearing about events that are supposed to take place, I ignore all of this. Having said that, if I was going to pay attention to anyone, it would be Loomer. She does seem to have some good sources, and is rarely proven wrong. She could very well be wrong, and I hope she is, but if I was a betting person, I’d put my money on her as opposed to all of these Q grifters.
704
posted on
07/08/2024 12:39:18 PM PDT
by
JudyinCanada
(The left is loathsome, beyond anything I could have believed.)
To: MagUSNRET
Lol I think Mike Lindell is an amazing patriot and his passion for America is unbelievable. I also will be quite fine if I never hear another My Pillow ad!
705
posted on
07/08/2024 12:41:28 PM PDT
by
JudyinCanada
(The left is loathsome, beyond anything I could have believed.)
To: JudyinCanada
For quite some time now Gerber has had several different nationalities and types as their Gerber baby of the year. Back in 2018 they featured a Downs Syndrome baby. My gosh has it been that long ago. It seems like yesterday I saw that article.
This link has pictures of all of them. Orientals etc; What I don’t understand is why are they calling this the first Black Baby for this year? Or did they say the first Black Boy? I will have to go back and check because as I looked through all the pictures in this link 2011 looked like a Black Girl to me.
https://people.com/parents/gerber-photo-search-winners-through-the-years/
Today is 107 and they say tomorrow will be 111. I am hybernating indoors with my air conditioner.
706
posted on
07/08/2024 1:09:18 PM PDT
by
Spunky
(Computers do crazy things.)
To: MagUSNRET
“I tried to listen tothe WH brieding,...”
Was that todays briefing?
707
posted on
07/08/2024 1:10:58 PM PDT
by
Spunky
(Computers do crazy things.)
To: JudyinCanada
“Having said that, if they started slapping homosexual couples and drag queens or obvious weirdos on packages, I’d definitely go without it.”
I probably would also. One thing that has me pissed is I have Peacock and their is this commercial about protecting yourself from HIV. They show a couple Gays cuddling. Peacock won’t allow you to fast forward through the commercials. You can the program, but not the commercials. Grrrr!!!!
708
posted on
07/08/2024 1:15:51 PM PDT
by
Spunky
(Computers do crazy things.)
To: DollyCali
Well, That is a lot of suplimentes. I don’t know, glad I didn’t get the shot.
709
posted on
07/08/2024 1:36:40 PM PDT
by
norsky
(<P><h3> <P><img src=" "width=500"></img> <P> <a href= > </a> )
To: MayflowerMadam
That does make sense.
I never really had much experience with black people until I started tutoring at a high school that took in kids that were kicked out of other High schools. Horrible job as you could imagine. But for some reason I hired a whole lot of black people and hispanics. The white teachers would socialize with anybody. Hispanics did as well. But not the blacks, they stuck to their own. Sad story, one of the black tutors was a smart girl that she had already had two illegitimate babies. With guys not in the picture. And she was considered the success story of her family because she’s going to college. So many bad choices and she was so young.
710
posted on
07/08/2024 1:45:16 PM PDT
by
CottonBall
(When people fear government, there is TYRANNY. When government fears people, there is LIBERTY. )
To: stylin19a
That was excellent information on child internet dangers.
711
posted on
07/08/2024 1:46:24 PM PDT
by
norsky
(<P><h3> <P><img src=" "width=500"></img> <P> <a href= > </a> )
To: Nea Wood
“Like the burglar breaking into someone’s home. Or the dumb doofus white husband whose wife and kids are smarter than he is. Someone has to be the dope using the wrong product.”
That is so true. The way the white males are portrayed you wouldn’t think they were contributing the majority of our taxes.
712
posted on
07/08/2024 1:46:38 PM PDT
by
CottonBall
(When people fear government, there is TYRANNY. When government fears people, there is LIBERTY. )
To: Spunky
I should have done more extensive research on the Gerber babies. I guess clicking onto Amazon and looking at the pics on the current products doesn’t cut it lol.
That’s why you’re the Queen of Research, Spunky!
Wow, that is hot. I don’t know when the last time (if ever) we hit 100 degrees here, but I know for sure I’d be holed up inside as well!
713
posted on
07/08/2024 1:51:46 PM PDT
by
JudyinCanada
(The left is loathsome, beyond anything I could have believed.)
To: Spunky
I looked it up! We reached 109 degrees in Ontario in 1975. I don’t remember that, but, whatever. I obviously survived it, but I sure wouldn’t now without air!
714
posted on
07/08/2024 1:57:39 PM PDT
by
JudyinCanada
(The left is loathsome, beyond anything I could have believed.)
To: JudyinCanada
After doing more research it appears the orginal Gerber Baby has remained on the baby food products.
“The original Gerber baby, Ann Turner Cook, died on Friday, according to an announcement from Gerber on Instagram. “Gerber is deeply saddened by the passing of Ann Turner Cook, the original Gerber baby, whose face was sketched to become the iconic Gerber logo more than 90 years ago.Jun 4, 2022
She was 95.
So it seems that the Gerber babies since 2011 was just a contest for a baby to be recognized as a Gerber Baby of the year.
Now maybe since she has passed away this Black Boy may be going on the jars, so he would be the first. Keep an eye out.
715
posted on
07/08/2024 2:07:44 PM PDT
by
Spunky
(Computers do crazy things.)
To: DollyCali
Following up on the vax, her is a short vid of a MD showing what the vax does to blood on an electron microscope. The cells are destroyed, and fluid leaves the cells, the donate shape of the red cell collapses so it can no longer carry O2. Very devastating to the blood. LEAKED – COVID-19 Vaccines Containing NanoChips: "What happens when a drop of Covid vaccine from different manufacturers is added to a blood sample? Journalist Bigtrees conducted this experiment in the laboratory of pathologist Dr. Ryan Cole, with surprising results! "The blood changes immediately, I've never seen anything like it! ... It's not because of the spike, but because of the nanoparticles." But see for yourself."
https://x.com/i/status/1809390986898149716LEAKED – COVID-19 Vaccines Containing NanoChips
716
posted on
07/08/2024 2:11:57 PM PDT
by
norsky
(<P><h3> <P><img src=" "width=500"></img> <P> <a href= > </a> )
To: JudyinCanada
Growing up here I recall many summers of 110+ with no air-conditioning. We had a fan and I remember my mother putting a cold towel in front of it. No air in cars just wing windows.
The year we moved back here from Calif. in July 1979 it was 115. Thankfully we had air conditioning then.
717
posted on
07/08/2024 2:12:43 PM PDT
by
Spunky
(Computers do crazy things.)
To: exit82
718
posted on
07/08/2024 2:13:02 PM PDT
by
CottonBall
(When people fear government, there is TYRANNY. When government fears people, there is LIBERTY. )
To: Spunky
I think I remember her passing away. Gerber has been around a long time. Never used any of it....none of us have. Cute baby, but I think my smallest granddaughter is cuter lol. Then again, don’t we all?
719
posted on
07/08/2024 2:13:06 PM PDT
by
JudyinCanada
(The left is loathsome, beyond anything I could have believed.)
To: norsky
OK, this sounds bad but I needed explained in english.
720
posted on
07/08/2024 2:14:02 PM PDT
by
CottonBall
(When people fear government, there is TYRANNY. When government fears people, there is LIBERTY. )
Navigation: use the links below to view more comments.
first previous 1-20 ... 681-700, 701-720, 721-740 ... 5,641 next last
Disclaimer:
Opinions posted on Free Republic are those of the individual
posters and do not necessarily represent the opinion of Free Republic or its
management. All materials posted herein are protected by copyright law and the
exemption for fair use of copyrighted works.
FreeRepublic.com is powered by software copyright 2000-2008 John Robinson








